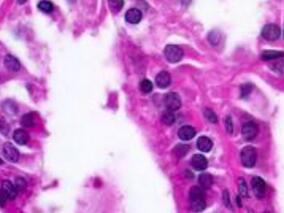
女32岁，心悸、多汗、腹泻14年，胸闷气短6个月，甲亢复发还是另有病因
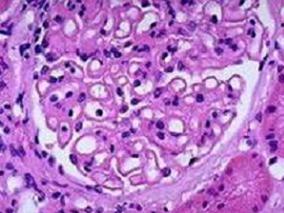
男48岁，发现尿糖阳性半个月，但血糖正常

-
手足麻木2年,加重伴间断四肢搐搦16天,四肢抽搐入…
环球医学资讯
2016年12月20日
点击量:359
1小时条评论患者女性,29岁,于2009年2月16日入院。 一、主诉 手足麻木2年,加重伴间断四肢搐搦16天。 二、病史询问 (一)初步诊断思路及问诊目的 患者年龄相对较轻,病史大约2年,近期症状加重,并出现四肢搐搦,依据临床表现首先考虑低钙血症,其次要考虑低钾血症等情况...
-
女17岁,双下肢无力1年余,加重1月,新斯的明试验阴性
环球医学资讯
2016年12月16日
点击量:588
1小时条评论女,17岁,右利手。 主诉:双下肢无力1年余,加重1月。 病史:患者于2004年8月无明显诱因下出现双下肢乏力,平地行走数百米后需要休息,上楼梯有时需要扶把手,蹲下后可自行起立,但觉费力,下楼梯无明显费力,自觉上肢力气没有影响,症状无晨轻暮重,但运动不耐疲...
-
女35岁,泌乳、闭经7年,双下肢畸形2年,骨痛6个月…
环球医学资讯
2016年12月14日
点击量:447
1小时条评论患者女性,35岁,于2010年12月4日入院。 一、主诉 泌乳、闭经7年,双下肢畸形2年,骨痛6个月。 二、病史询问 (一)初步诊断思路及问诊目的 患者中年女性,以泌乳、闭经为首发症状,首先考虑为催乳素瘤。患者之后出现双下肢畸形、骨痛,提醒我们注意有无多发性...
-
女69岁,怕冷、少语、反应差25年,活动后气短伴头昏…
环球医学资讯
2016年12月14日
点击量:273
1小时条评论患者女性,69岁,于2009年05月15日入院。 一、主诉 怕冷、少语、反应差25年,活动后气短伴头昏3月余。 二、病史询问 (一)初步诊断思路及问诊目的 患者老年女性,怕冷、少语、反应差25年,3个月前出现活动后气短伴头晕。首先考虑常见病,是否为甲状腺功能减退...
-
女69岁,精神异常2年,顽固便秘2个月,肛裂肠梗阻
环球医学资讯
2016年12月08日
点击量:532
1小时条评论患者女性,69岁,于2011年1月14日入院。 一、主诉 精神异常2年,顽固便秘2个月。 二、病史询问 (一)初步诊断思路及问诊目的 患者老年女性,出现精神异常2年,便秘2个月。应仔细问诊患者精神异常何时出现,诱因,是否受到某种精神刺激,是否有颅脑外伤史或颅内...
-
女32岁,心悸、多汗、腹泻14年,胸闷气短6个月,甲…
环球医学资讯
2016年12月08日
点击量:296
1小时条评论患者女性,32岁,于2010年11月9日入院。 一、主诉 心悸、多汗、腹泻14年,胸闷气短6个月,肝功能异常1周。 二、病史询问 (一)初步诊断思路及问诊目的 患者青年女性,14年前无明显诱因出现心慌、多汗、腹泻等症状,就诊于当地医院,查甲状腺功能示值高(具体不...
-
女41岁,恶心、呕吐6年,产后大出血,眉毛、腋毛、…
环球医学资讯
2016年12月02日
点击量:423
1小时条评论患者女性,41岁,于2008年10月13日入院。 一、主诉 怕冷、乏力、纳差、间断恶心、呕吐6年,加重10天。 二、病史询问 (一)初步诊断思路及问诊目的 对于恶心、呕吐这一症状,临床中可见于许多疾病,涉及多个专业,可以是消化系统疾病的表现,也可以是其他专业疾...
-
女48岁,间断手足麻木、抽搐2年,偶有双下肢水肿
环球医学资讯
2016年12月02日
点击量:469
1小时条评论患者女性,48岁,于2010年12月22日入院。 一、主诉 间断手足麻木、抽搐2年。 二、病史询问 (一)初步诊断思路及问诊目的 患者为中年女性,间断性手足麻木、抽搐2年,临床应首先考虑内科疾病如电解质紊乱,常见于低钾血症、低钙血症等。患者发作时具有严重的低...
-
男48岁,发现尿糖阳性半个月,但血糖正常
环球医学资讯
2016年11月28日
点击量:646
1小时条评论患者男性,48岁,于2008年7月8日入院。 一、主诉 尿糖阳性半个月。 二、询问病史 (一)诊断思路及问诊目的 患者中年男性,新近发现尿糖阳性,但患者血糖正常,且无多饮、多尿、多食、消瘦症状,故可除外糖尿病,考虑肾性糖尿。肾性糖尿是肾小管性疾病,分为先...
-
男33岁,发作性双下肢乏力2天,体格检查无明显阳性…
环球医学资讯
2016年11月28日
点击量:1468
1小时条评论患者男性,33岁,于2011年7月11日入院。 一、主诉 发作性双下肢乏力2天。 二、病史询问 (一)初步诊断思路及问诊目的 患者青年男性,本次入院主因发作性双下肢乏力。问诊主要围绕着乏力发生的原因。一般临床出现对称性下肢无力主要考虑低钾血症所致。按常见病...

会员登录

